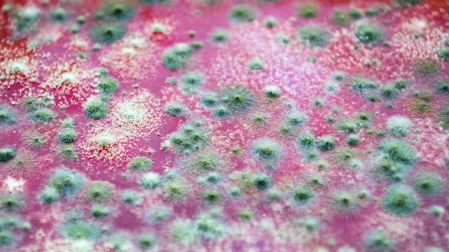
thumb

Hongo mortal de la “maldición de Tutankamón” podría ser un potente fármaco contra el cáncer
El hongo de la tumba de Tutankamón podría combatir el cáncer. Hallazgo científico 2025 que transforma una maldición en posible medicina del futuro.

Entre las sombras de la historia y el polvo eterno del desierto egipcio, un nuevo hallazgo sacude la ciencia moderna: un hongo mortal hallado en la tumba de Tutankamón podría combatir el cáncer. Lo que por décadas se relacionó con la “maldición del faraón” hoy podría salvar vidas.
Según un reciente estudio publicado en Nature Chemical Biology (Nature, 2025), el microorganismo detectado en las paredes del sepulcro tiene propiedades bioactivas únicas. Lo que parecía una amenaza biológica ha resultado ser un posible aliado en la lucha contra ciertos tipos de cáncer en la sangre, como la leucemia.
¿Qué es el hongo encontrado en la tumba de Tutankamón y por qué es tan peligroso?
El hongo pertenece al género Aspergillus flavus, una especie que libera micotoxinas letales como la aflatoxina. Este tipo de hongo prospera en lugares húmedos y oscuros, como la tumba sellada del joven faraón.
Desde que Howard Carter abrió la cámara funeraria en 1922, varios investigadores murieron en circunstancias misteriosas. La ciencia actual sugiere que esporas tóxicas como estas pudieron estar involucradas.

También te puede interesar: ¿El hongo cordyceps puede afectar a los humanos? Esto es lo que dicen los expertos
¿Cómo podría un hongo mortal ayudar a combatir el cáncer?
La paradoja es sorprendente: el mismo hongo que puede causar enfermedades también podría contener compuestos anticancerígenos. Científicos están estudiando una molécula capaz de inducir apoptosis selectiva en células cancerosas.
Datos científicos clave
- Reducción del 60% en células leucémicas in vitro.
- Acción citotóxica sin afectar células sanas.
- Composición química distinta a otros hongos ya estudiados.
Investigaciones lideradas por el Institut Pasteur y el National Cancer Institute avanzan en ensayos preclínicos.

También te puede interesar: ¡Hongos en el Metro CDMX! Video exhibe microbios en tubos, torniquetes, etc…
¿Qué dice la ciencia sobre este hongo y su uso en medicina?
El hongo podría transformarse en un fármaco dirigido contra ciertos tipos de cáncer. El Dr. Marc Delorme, del INSERM, declaró que este tipo de hallazgos “confirma el valor de estudiar ambientes extremos en busca de nuevas moléculas terapéuticas”.
¿Este hongo representa un riesgo para investigadores o visitantes?
El llamado hongo misterioso de la tumba del faraón puede provocar aspergilosis, una infección respiratoria peligrosa. Hoy se utilizan protocolos de bioseguridad para proteger a quienes trabajan en zonas arqueológicas selladas.
En México, donde también existen sitios húmedos y cerrados, como cuevas prehispánicas o criptas coloniales, este hallazgo puede ser clave para actualizar protocolos sanitarios.
También te puede interesar: Hongo se propaga en los hospitales y preocupa a las autoridades de EU por alza en infecciones
¿Qué otras sustancias curativas se han hallado en tumbas o sitios arqueológicos?
Este hallazgo científico en Egipto 2025 no es único. A lo largo de la historia, arqueólogos han encontrado compuestos con propiedades curativas en contextos funerarios.
Sustancias curativas antiguas
- Resinas antibacterianas en momias egipcias (mirra, benjuí).
- Plantas conservadas con alcaloides medicinales en vasijas andinas.
- Pomadas y pastas dentales con efectos antisépticos.
Conclusión: del mito al microscopio, la cura también puede venir de una maldición
Lo que por años se temió como una maldición egipcia, hoy podría ser una bendición médica. Que un hongo tóxico encerrado durante milenios tenga la clave para combatir el cáncer es una lección de humildad científica.
En México y América Latina, donde la biodiversidad y el patrimonio arqueológico son vastos, este hallazgo invita a conservar, estudiar y valorar lo que duerme bajo tierra. Porque quizá ahí también se esconda una cura futura.



